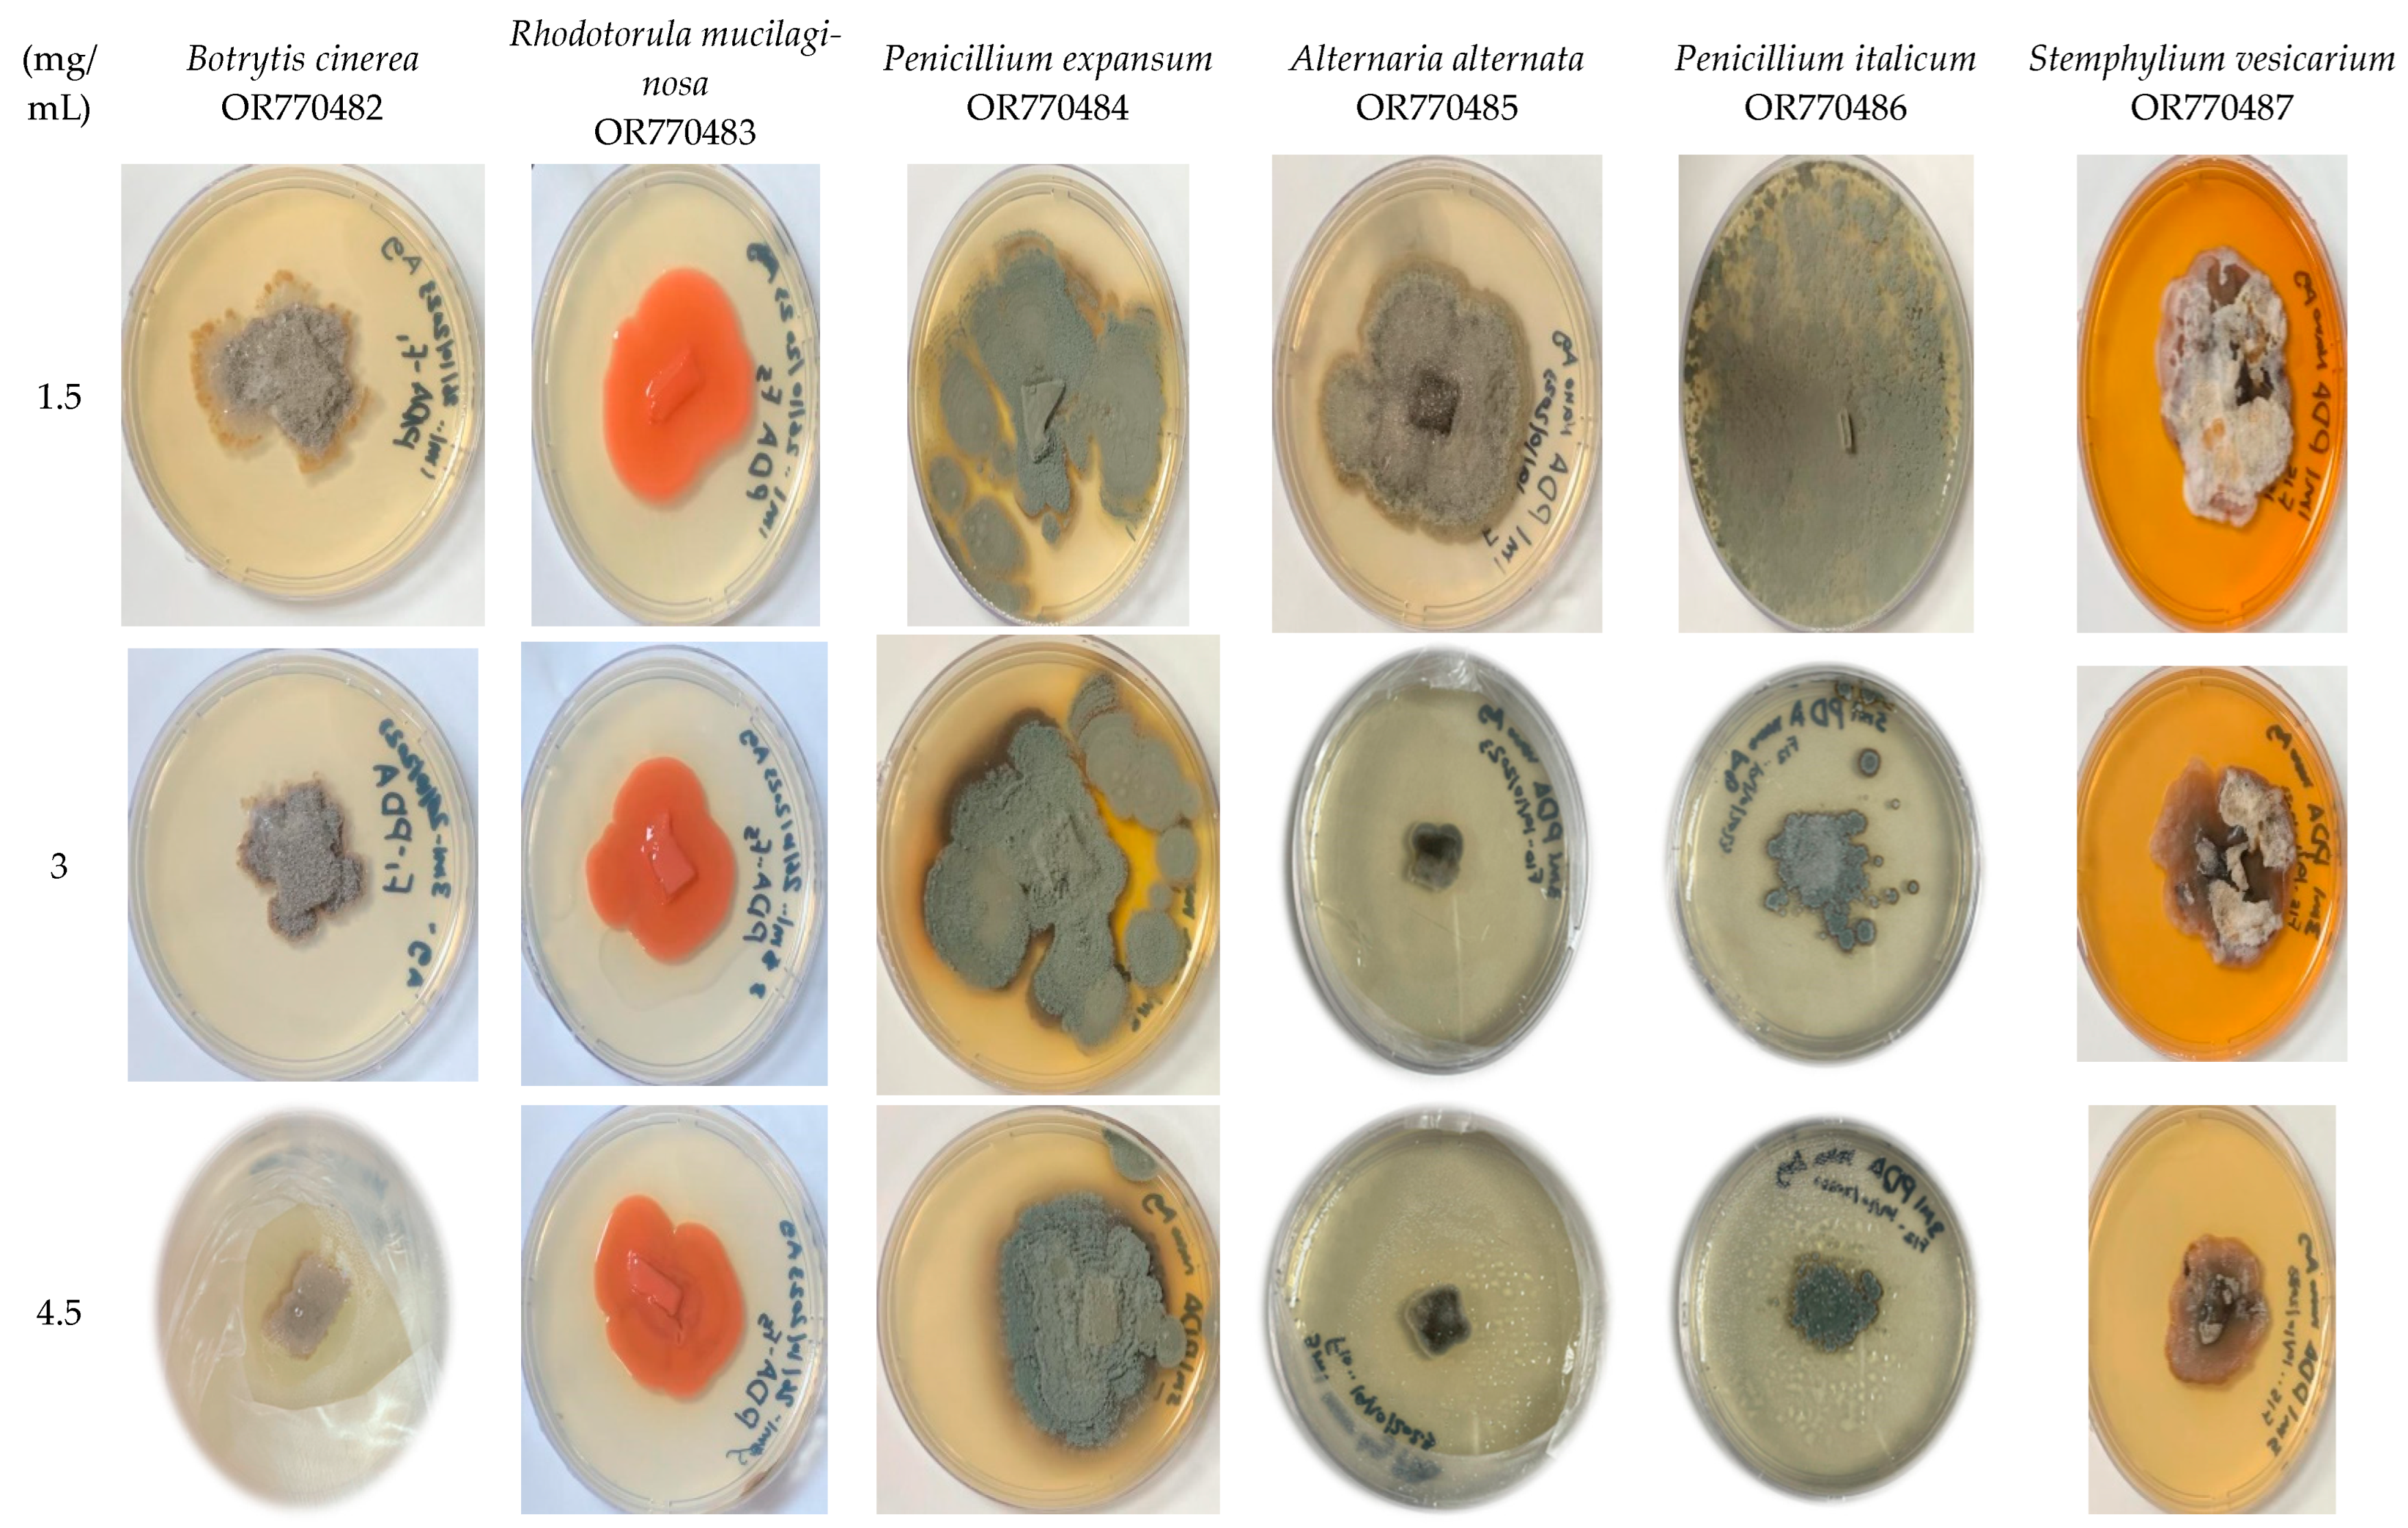
Marinedrugs 22 00225 g008

Antifungal Activities of Biogenic Silver Nanoparticles Mediated by Marine Algae: In Vitro and In Vivo Insights of Coating Tomato Fruit to Protect against Penicillium italicum Blue Mold
Abstract
1. Introduction
2. Results and Discussion
2.1. FT-IR Analysis of Marine Alga Turbinaria Turbinata
2.2. Nanoparticles’ Characterization
2.3. Identification and Phylogenetic Analysis
2.4. Pathogenicity Tests
2.5. Determination of Physical and Chemical Characteristics
2.6. Relationship of Postharvest Tomato Characteristics
3. Materials and Methods
3.1. Preparation of Silver Nanoparticles
3.1.1. Alga Collection
3.1.2. Algal Extract
3.1.3. Biosynthesis Silver Nanoparticles (Tt/Ag-NPS)
3.1.4. Silver Nanoparticles’ Characterization
FT-IR
Transmission Electron Microscopy (TEM)
XRD Analysis
Energy-Dispersive Spectroscopy and SEM
Zeta Potential
3.2. Fungi Isolation
3.2.1. Identification and Phylogenetic Tree of Fungi
3.2.2. In Vitro Antifungal Activities
3.2.3. Determination of Susceptibility of Tomato Fruits to the Pathogen’s Strains
3.3. Silver Nanoparticles Used in the Preservation of Tomato
Chilling Injury Index and Incidence
3.4. Physical and Chemical Characteristics’ Determination
3.4.1. Weight Loss (%)
3.4.2. Titratable Acidity (TA) and pH Measurements
3.4.3. Total Lycopene and Carotenoids
3.4.4. Tomato Fruit Extraction
3.4.5. Total Phenolic
3.4.6. Determination of Free Radical Scavenging Activity (DPPH)
3.4.7. Total Soluble Solids (TSS %)
3.5. Statistical Analysis
4. Conclusions
Author Contributions
Funding
Data Availability Statement
Acknowledgments
Conflicts of Interest
References
- Shah, K.K.; Modi, B.; Lamsal, B.; Shrestha, J.; Aryal, S.P. Bioactive compounds in tomato and their roles in disease prevention. Fundam. Appl. Agric. 2021, 6, 210–224. [Google Scholar] [CrossRef]
- Zabo, K.; Cătoi, A.F.; Vodnar, D.C. Bioactive Compounds Extracted from Tomato Processing by-Products as a Source of Valuable Nutrients. Plant Foods Hum. Nutr. 2018, 73, 268–277. [Google Scholar] [CrossRef]
- Xie, G.; Tan, S.; Yu, L. Morphological and molecular identification of pathogenic fungal of post-harvest tomato fruit during storage. Afr. J. Microbiol. Res. 2012, 6, 4805–4809. [Google Scholar] [CrossRef]
- Vitoratos, A.; Bilalis, D.; Karkanis, A.; Efthimiadou, A. Antifungal activity of plant essential oils against Botrytis cinerea, Penicillium italicum and Penicillium digitatum. Not. Bot. Horti Agrobot. Cluj-Napoca 2013, 41, 86–92. [Google Scholar] [CrossRef]
- Kanashiro, A.M.; Akiyama, D.Y.; Kupper, K.C.; Fill, T.P. Penicillium italicum: An underexplored postharvest pathogen. Front. Microbiol. 2020, 11, 606852. [Google Scholar] [CrossRef] [PubMed]
- Xu, X.; Qin, G.; Tian, S. Effect of microbial biocontrol agents on alleviating oxidative damage of peach fruit subjected to fungal pathogen. Int. J. Food Microbiol. 2008, 126, 153–158. [Google Scholar] [CrossRef] [PubMed]
- Meng, X.; Yang, L.; Kennedy, J.F.; Tian, S. Effects of chitosan and oligochitosan on growth of two fungal pathogens and physiological properties in pear fruit. Carbohydr. Polym. 2010, 81, 70–75. [Google Scholar] [CrossRef]
- Sharifan, H.; Noori, A.; Bagheri, M.; Moore, J.M. Postharvest spraying of zinc oxide nanoparticles enhances shelf life qualities and zinc concentration of tomato fruits. Crop Pasture Sci. 2021, 2021, 1–10. [Google Scholar] [CrossRef]
- Elatafi, E.; Fang, J. Effect of silver nitrate (AgNO3) and nano-silver (Ag-NPs) on physiological characteristics of grapes and quality during storage period. Horticulturae 2022, 8, 419. [Google Scholar] [CrossRef]
- Gudadhe, J.A.; Rai, M.; Yadav, A.; Durán, N.; Marcato, P.D.; Gade, A. Preparation of an agar-silver nanoparticles (A-AgNp) film for increasing the shelf-life of fruits. IET Nanobiotechnol. 2014, 8, 190–195. [Google Scholar] [CrossRef]
- Incoronato, A.L.; Conte, A.; Buonocore, G.G.; Del Nobile, M.A. Agar hydrogel with silver nanoparticles to prolong the shelf life of Fior di Latte cheese. J. Dairy Sci. 2011, 94, 1697–1704. [Google Scholar] [CrossRef] [PubMed]
- Salem, E.A.; Nawito, M.A.S.; Abd El-Raouf, A.E.R. Effect of silver nano-particles on gray mold of tomato fruits. J. Nanotechnol. Res. 2019, 1, 108–118. [Google Scholar]
- Sunday, J.O.; Sadiat, H.S.; Akpenpuun, T.D. Determination of the Effects of Silver Nano-Particle Packaging Materials on Storability of Tomatoes. FUOYE J. Eng. Technol. 2023, 8, 2579–2625. [Google Scholar] [CrossRef]
- Yadav, A.; Kumar, N.; Upadhyay, A.; Sethi, S.; Singh, A. Edible coating as postharvest management strategy for shelf-life extension of fresh tomato (Solanum lycopersicum L.): An overview. J. Food Sci. 2022, 87, 2256–2290. [Google Scholar] [CrossRef] [PubMed]
- Hernández-Fuentes, A.D.; López-Vargas, E.R.; Pinedo-Espinoza, J.M.; Campos-Montiel, R.G.; Valdés-Reyna, J.; Juárez-Maldonado, A. Postharvest behavior of bioactive compounds in tomato fruits treated with Cu nanoparticles and NaCl stress. Appl. Sci. 2017, 7, 980. [Google Scholar] [CrossRef]
- Mansourbahmani, S.; Ghareyazie, B.; Zarinnia, V.; Kalatejari, S.; Mohammadi, R.S. Study on the efficiency of ethylene scavengers on the maintenance of postharvest quality of tomato fruit. J. Food Meas. Charact. 2017, 12, 691–701. [Google Scholar] [CrossRef]
- Neysanian, M.; Iranbakhsh, A.; Ahmadvand, R.; Oraghi Ardebili, Z.; Ebadi, M. Comparative efficacy of selenate and selenium nanoparticles for improving growth, productivity, fruit quality, and postharvest longevity through modifying nutrition, metabolism, and gene expression in tomato; potential benefits and risk assessment. PLoS ONE 2020, 15, e0244207. [Google Scholar] [CrossRef]
- Manaa, H.M.; Hamza, E.M.; Sorour, N.M. Post-harvest biocontrol of Fusarium infection in tomato fruits using bio-mediated selenium nanoparticles. AMB Express 2023, 13, 119. [Google Scholar] [CrossRef] [PubMed]
- Mahdavi, M.; Namvar, F.; Ahmad, M.B.; Mohamad, R. Green biosynthesis and characterization of magnetic iron oxide (Fe3O4) nanoparticles using seaweed (Sargassum muticum) aqueous extract. Molecules 2013, 18, 5954–5964. [Google Scholar] [CrossRef]
- Hamouda, R.A.; Aljohani, E.S. Assessment of Silver Nanoparticles Derived from Brown Algae Sargassum vulgare: Insight into Antioxidants, Anticancer, Antibacterial and Hepatoprotective Effect. Mar. Drugs 2024, 22, 154. [Google Scholar] [CrossRef]
- Hamouda, R.A.; Alharthi, M.A.; Alotaibi, A.S.; Alenzi, A.M.; Albalawi, D.A.; Makharita, R.R. Biogenic Nanoparticles Silver and Copper and Their Composites Derived from Marine Alga Ulva lactuca: Insight into the Characterizations, Antibacterial Activity, and AntiBiofilm Formation. Molecules 2023, 28, 6324. [Google Scholar] [CrossRef]
- Rajesh, S.; Raja, D.P.; Rathi, J.M.; Sahayaraj, K. Biosynthesis of silver nanoparticles using Ulva fasciata (Delile) ethyl acetate extract and its activity against Xanthomonas campestris pv. malvacearum. J. Biopestic. 2012, 5, 119. [Google Scholar]
- Vijayan, S.R.; Santhiyagu, P.; Singamuthu, M.; Kumari Ahila, N.; Jayaraman, R.; Ethiraj, K. Synthesis and characterization of silver and gold nanoparticles using aqueous extract of seaweed, Turbinaria conoides, and their antimicrofouling activity. Sci. World J. 2014, 2014, 938272. [Google Scholar] [CrossRef] [PubMed]
- Martinez-Molina, E.C.; Freile-Pelegrin, Y.; Ovando-Chacon, S.L.; Gutierrez-Miceli, F.A.; Ruiz-Cabrera, M.A.; Grajales-Lagunes, A.; Abud-Archila, M. Development and characterization of alginate-based edible film from Sargassum fluitans incorporated with silver nanoparticles obtained by green synthesis. J. Food Meas. Charact. 2022, 16, 126–136. [Google Scholar] [CrossRef]
- Farooqui, M.A.; Chauhan, P.S.; Krishnamoorthy, P.; Shaik, J. Extraction of silver nanoparticles from the leaf extracts of Clerodendrum inerme. Dig. J. Nanomater. Biostruct. 2010, 5, 43–49. [Google Scholar]
- Portaccio, M.; Della Ventura, B.; Mita, D.G.; Manolova, N.; Stoilova, O.; Rashkov, I.; Lepore, M. FT-IR microscopy characterization of sol–gel layers prior and after glucose oxidase immobilization for biosensing applications. J. Sol-Gel Sci. Technol. 2011, 57, 204–211. [Google Scholar] [CrossRef]
- Liao, L.F.; Lien, C.F.; Shieh, D.L.; Chen, F.C.; Lin, J.L. FTIR study of adsorption and photochemistry of amide on powdered TiO2: Comparison of benzamide with acetamide. Phys. Chem. Chem. Phys. 2002, 4, 4584–4589. [Google Scholar] [CrossRef]
- Hellwig, P.; Soulimane, T.; Mäntele, W. Electrochemical, FT-IR and UV/VIS spectroscopic properties of the caa3 oxidase from T. thermophilus. Eur. J. Biochem. 2002, 269, 4830–4838. [Google Scholar] [CrossRef] [PubMed]
- Lewis, P.D.; Lewis, K.E.; Ghosal, R.; Bayliss, S.; Lloyd, A.J.; Wills, J.; Godfrey, R.; Kloer, P.; Mur, L.A. Evaluation of FTIR spectroscopy as a diagnostic tool for lung cancer using sputum. BMC Cancer 2010, 10, 640. [Google Scholar] [CrossRef]
- Toubal, K.; Boukabcha, N.; Tamer, Ö.; Benhalima, N.; Altürk, S.; Avcı, D.; Hamzaoui, F. Spectroscopic (FT-IR, 1H and 13C NMR) characterization and density functional theory calculations for (Z)-5-(4-nitrobenzyliden)-3-N (2-ethoxyphenyl)-2-thioxo-thiazolidin-4-one (ARNO). J. Mol. Struct. 2017, 1147, 569–581. [Google Scholar] [CrossRef]
- Zhang, G.; Liu, Y.; Gao, X.; Chen, Y. Synthesis of silver nanoparticles and antibacterial property of silk fabrics treated by silver nanoparticles. Nanoscale Res. Lett. 2014, 9, 216. [Google Scholar] [CrossRef] [PubMed]
- Rajeshkumar, S.; Malarkodi, C.; Paulkumar, K.; Vanaja, M.; Gnanajobitha, G.; Annadurai, G. Algae mediated green fabrication of silver nanoparticles and examination of its antifungal activity against clinical pathogens. Int. J. Met. 2014, 2014, 692643. [Google Scholar] [CrossRef]
- Wang, X.; Yang, J.; Jiang, X.; Yu, L. Preparation and Properties of Environmentally Friendly Marine Antifouling Coatings Based on a Collaborative Strategy. Langmuir 2022, 38, 6676–6689. [Google Scholar] [CrossRef]
- Subramani, M.; Sepperumal, U. FTIR analysis of bacterial mediated chemical changes in polystyrene foam. Ann. Biol. Res. 2016, 7, 55–61. [Google Scholar]
- Sivakumar, S.R. Synthesis of Silver nanoparticles using bioactive seaweeds against poultry pathogens. Indo Am. J. Pharmaceut. Res. 2017, 7, 1. [Google Scholar] [CrossRef]
- Ikram, M.; Raja, N.I.; Javed, B.; Mashwani, Z.U.R.; Hussain, M.; Hussain, M.; Ehsan, M.; Rafique, N.; Malik, K.; Sultana, T.; et al. Foliar applications of bio-fabricated selenium nanoparticles to improve the growth of wheat plants under drought stress. Green Process. Synth. 2020, 9, 706–714. [Google Scholar] [CrossRef]
- Abdellatif, K.F.; Abdelfattah, R.H.; El-Ansary, M.S.M. Green nanoparticles engineering on root-knot nematode infecting eggplants and their effect on plant DNA modification. Iran. J. Biotechnol. 2016, 14, 250. [Google Scholar] [CrossRef] [PubMed]
- Majeed Khan, M.A.; Kumar, S.; Ahamed, M.; Alrokayan, S.A.; AlSalhi, M.S. Structural and thermal studies of silver nanoparticles and electrical transport study of their thin films. Nanoscale Res. Lett. 2011, 6, 434. [Google Scholar] [CrossRef] [PubMed]
- Akintelu, S.A.; Folorunso, A.S.; Ademosun, O.T. Instrumental characterization and antibacterial investigation of silver nanoparticles synthesized from Garcinia kola leaf. J. Drug Deliv. Ther. 2019, 9, 58–64. [Google Scholar] [CrossRef]
- Jayaprakash, N.; Vijaya, J.J.; Kennedy, L.J.; Priadharsini, K.; Palani, P. Antibacterial activity of silver nanoparticles synthesized from serine. Mater. Sci. Eng. C 2015, 49, 316–322. [Google Scholar] [CrossRef]
- Abo-Elmagd, R.A.; Hussein, M.H.; Hamouda, R.A.; Shalan, A.E.; Abdelrazak, A. Statistical optimization of photo-induced biofabrication of silver nanoparticles using the cell extract of Oscillatoria limnetica: Insight on characterization and antioxidant potentiality. RSC Adv. 2020, 10, 44232–44246. [Google Scholar] [CrossRef] [PubMed]
- Phongtongpasuk, S.; Poadang, S.; Yongvanich, N. Green synthetic approach to prepare silver nanoparticles using longan (Dimocarpus longan) peel extract and evaluation of their antibacterial activities. Mater. Today Proc. 2017, 4, 6317–6325. [Google Scholar] [CrossRef]
- Moldovan, B.; David, L.; Achim, M.; Clichici, S.; Filip, G.A. A green approach to phytomediated synthesis of silver nanoparticles using Sambucus nigra L. fruits extract and their antioxidant activity. J. Mol. Liq. 2016, 221, 271–278. [Google Scholar] [CrossRef]
- Priyadarshini, S.; Gopinath, V.; Priyadharsshini, N.M.; MubarakAli, D.; Velusamy, P. Synthesis of anisotropic silver nanoparticles using novel strain, Bacillus flexus and its biomedical application. Colloids Surf. B Biointerfaces 2013, 102, 232–237. [Google Scholar] [CrossRef] [PubMed]
- Raj, C.D.; Muthukumar, K.; Dahms, H.U.; James, R.A.; Kandaswamy, S. Structural characterization, antioxidant and anti-uropathogenic potential of biogenic silver nanoparticles using brown seaweed Turbinaria ornata. Front. Microbiol. 2023, 14, 1072043. [Google Scholar] [CrossRef] [PubMed]
- Periaswamy Sivagnanam, S.; Tilahun Getachew, A.; Choi, J.H.; Park, Y.B.; Woo, H.C.; Chun, B.S. Green synthesis of silver nanoparticles from deoiled brown algal extract via Box-Behnken based design and their antimicrobial and sensing properties. Green Process. Synth. 2017, 6, 147–160. [Google Scholar] [CrossRef]
- Derbalah, A.S.; Elkot, G.A.E.; Hamza, A.M. Laboratory evaluation of botanical extracts, microbial culture filtrates and silver nanoparticles against Botrytis cinerea. Ann. Microbiol. 2012, 62, 1331–1337. [Google Scholar] [CrossRef]
- Ali, J.; Mazumder, J.A.; Perwez, M.; Sardar, M. Antimicrobial effect of ZnO nanoparticles synthesized by different methods against food borne pathogens and phytopathogens. Mater. Today Proc. 2021, 36, 609–615. [Google Scholar] [CrossRef]
- Kayalvizhi, K.; Asmathunisha, N.; Subramanian, V.; Kathiresan, K. Purification of silver and gold nanoparticles from two species of brown seaweeds (Padina tetrastromatica and Turbinaria ornata). J. Med. Plants Stud. 2014, 2, 32–37. [Google Scholar]
- Kim, S.W.; Jung, J.H.; Lamsal, K.; Kim, Y.S.; Min, J.S.; Lee, Y.S. Antifungal effects of silver nanoparticles (AgNPs) against various plant pathogenic fungi. Mycobiology 2012, 40, 53–58. [Google Scholar] [CrossRef]
- Madbouly, A.K. The Efficacy of Green Synthesized Nanosilver in Reducing the Incidence of Post-Harvest Apple Fruit Brown Rot. J. Fungi 2021, 7, 473. [Google Scholar] [CrossRef] [PubMed]
- Samson, R.A.; Houbraken, J.; Thrane, U.; Frisvad, J.C.; Andersen, B. Food and Indoor Fungi; Westerdijk Fungal Biodiversity Institute: Utrecht, The Netherlands, 2019; Volume 2. [Google Scholar]
- Barboráková, Z.; Jakabova, S.; Maskova, Z.; Mrvova, M.; Uzsákova, V.; Makova, J.; Tancinova, D. Toxin Producing Micromycetes of the Genus Penicillium and Aspergillus on Berries, Grapes, and Tomato Fruits in Slovak Stores. J. Microbiol. Biotechnol. Food Sci. 2023, 13, e9927. [Google Scholar] [CrossRef]
- Miedes, E.; Lorences, E.P. Changes in cell wall pectin and pectinase activity in apple and tomato fruits during Penicillium expansum infection. J. Sci. Food Agric. 2006, 86, 1359–1364. [Google Scholar] [CrossRef]
- Kalyoncu, F. Determination of fungi associated with tomatoes (Lycopersicum esculentum M.) and tomato pastes fatih kalyoncu, A. usame tamer and mustafa oskay. Plant Pathol. J. 2005, 4, 146–149. [Google Scholar] [CrossRef]
- Albornoz, K.; Cantwell, M.I.; Zhang, L.; Beckles, D.M. Integrative analysis of postharvest chilling injury in cherry tomato fruit reveals contrapuntal spatio-temporal responses to ripening and cold stress. Sci. Rep. 2019, 9, 2795. [Google Scholar] [CrossRef]
- Taye, A.M.; Tilahun, S.; Seo, M.H.; Jeong, C.S. Effects of continuous application of CO2 on fruit quality attributes and shelf life during cold storage in cherry tomato. Hortic. Sci. Technol. 2017, 35, 300–313. [Google Scholar]
- Mandal, D.; Sailo, L.; Hazarika, T.K.; Shukla, A.C. Effect of edible coating on shelf life and quality of local mango cv. Rangkuai of Mizoram. Res. Crops 2018, 19, 419–424. [Google Scholar]
- Afolabi, A.S.; Choi, I.L.; Lee, J.H.; Kwon, Y.B.; Yoon, H.S.; Kang, H.M. Effect of Pre-Storage CO2 Treatment and Modified Atmosphere Packaging on Sweet Pepper Chilling Injury. Plants 2023, 12, 671. [Google Scholar] [CrossRef]
- Huynh, M.D.; Linh, N.T.D.; Chinh, N.T.; Trang, N.T.T.; Manh, V.Q.; Linh, N.N.; Trung, V.Q. Preparation of preservative coating for tomatoes based on polyphenol modified chitosan and silver nanoparticles. Vietnam J. Chem. 2022, 60, 86–95. [Google Scholar] [CrossRef]
- Adjouman, Y.D.; Nindjin, C.; Kouassi, K.N.; Tetchi, F.A.; N’Guessan, G.A.; Sindic, M. Effect of edible coating based on improved cassava starch on post-harvest quality of fresh tomatoes (Solanum lycopersicum L.). Int. J. Nutr. Sci. Food Technol. 2018, 4, 1–10. [Google Scholar]
- Firdous, N.; Khan, M.R.; Butt, M.S.; Shahid, M. Application of aloevera gel based edible coating to maintain postharvest quality of tomatoes. Pak. J. Agric. Sci. 2020, 57, 235–249. [Google Scholar]
- Tzortzakis, N. Physiological and proteomic approaches to address the active role of Botrytis cinerea inoculation in tomato postharvest ripening. Microorganisms 2019, 7, 681. [Google Scholar] [CrossRef] [PubMed]
- Zorn, H.; Langhoff, S.; Scheibner, M.; Berger, R.G. Cleavage of β, β-carotene to flavor compounds by fungi. Appl. Microbiol. Biotechnol. 2003, 62, 331–336. [Google Scholar] [CrossRef]
- Mustafa, M.A.; Ali, A.; Manickam, S. Application of a chitosan based nanoparticle formulation as an edible coating for tomatoes (Solanum lycoperiscum L.). Acta Hortic. 2012, 1012, 445–452. [Google Scholar] [CrossRef]
- Martinez-Romero, D.; Alburquerque, N.; Valverde, J.M.; Guillén, F.; Castillo, S.; Valero, D.; Serrano, M. Postharvest sweet cherry quality and safety maintenance by Aloe vera treatment: A new edible coating. Postharvest Biol. Technol. 2006, 39, 92–100. [Google Scholar] [CrossRef]
- Thammachote, N.; Sripong, K.; Uthairatanakij, A.; Laohakunjit, N.; Limmatvapirat, S.; Ma, G.; Jitareerat, P. Influence of silver nanoparticles on postharvest disease, pericarp hardening, and quality of mangosteen. Postharvest Biol. Technol. 2023, 204, 112470. [Google Scholar] [CrossRef]
- Das, D.; Mandal, P. Use of biogenic silver nanoparticles in enhancing shelf life of Morus alba L. at post harvest stage. Sci. Rep. 2020, 10, 8923. [Google Scholar] [CrossRef] [PubMed]
- Ali, M.; Ahmed, A.; Shah, S.W.A.; Mehmood, T.; Abbasi, K.S. Effect of silver nanoparticle coatings on physicochemical and nutraceutical properties of loquat during postharvest storage. J. Food Process. Preserv. 2020, 44, e14808. [Google Scholar] [CrossRef]
- Lichanporn, I.; Techavuthiporn, C.; Wongs-Aree, C. Effect of silver particle-longkong peel extract coating on postharvest decay and browning in longkong fruit. Hortic. J. 2020, 89, 328–336. [Google Scholar] [CrossRef]
- Shahat, M.S.; Ibrahim, M.I.; Osheba, A.S.; Taha, I.M. Preparation and characterization of silver nanoparticles and their use for improving the quality of apricot fruits. Al-Azhar J. Agric. Res. 2020, 45, 38–55. [Google Scholar] [CrossRef]
- Hmmam, I.; Zaid, N.; Mamdouh, B.; Abdallatif, A.; Abd-Elfattah, M.; Ali, M. Storage Behavior of “Seddik” Mango Fruit Coated with CMC and Guar Gum-Based Silver Nanoparticles. Horticulturae 2021, 7, 44. [Google Scholar] [CrossRef]
- Sharma, S.; Sharma, N.; Kaushal, N. Utilization of novel bacteriocin synthesized silver nanoparticles (AgNPs) for their application in antimicrobial packaging for preservation of tomato fruit. Front. Sustain. Food Syst. 2023, 7, 1072738. [Google Scholar] [CrossRef]
- Taylor, W.S. Marine Algae of the Eastern Tropical and Subtrobical Coasts of Americas; ANN Arbor the University of Michigan Press: Ann Arbor, MI, USA, 1985. [Google Scholar]
- Agnihotri, S.; Mukherji, S.; Mukherji, S. Immobilized silver nanoparticles enhance contact killing and show highest efficacy: Elucidation of the mechanism of bactericidal action of silver. Nanoscale 2013, 5, 7328–7340. [Google Scholar] [CrossRef] [PubMed]
- Mukhammadiev, R.S.; Skvortsov, E.V.; Valiullin, L.R.; Glinushkin, A.P.; Bagaeva, T.V. Isolation, Purification, and Characterization of a Lectin from the Fungus Fusarium solani 4. Appl. Biochem. Microbiol. 2021, 57, 206–211. [Google Scholar] [CrossRef]
- Tamura, K.; Stecher, G.; Kumar, S. MEGA 11: Molecular evolutionary genetics analysis version 11. Mol. Biol. Evol. 2021, 38, 3022–3027. [Google Scholar] [CrossRef] [PubMed]
- Hamouda, R.A.; Abdel-Hamid, M.S.; Hagagy, N.; Nofal, A.M. The potent effect of selenium nanoparticles insight into: The antifungal activity and preservation of postharvest strawberries from gray mold diseases. J. Sci. Food Agric. 2024, 2024, 1–13. [Google Scholar] [CrossRef] [PubMed]
- Nasr, F.; Pateiro, M.; Rabiei, V.; Razavi, F.; Formaneck, S.; Gohari, G.; Lorenzo, J.M. Chitosan-Phenylalanine Nanoparticles (Cs-Phe Nps) Extend the Postharvest Life of Persimmon (Diospyros kaki) Fruits under Chilling Stress. Coatings 2021, 11, 819. [Google Scholar] [CrossRef]
- Al-Obaidy, W.A.; Rabee, A.M. Calculation the air pollution tolerance index of eucalyptus plant in Baghdad city. Int. J. Adv. Biol. Res. 2018, 8, 250–254. [Google Scholar]
- Tang, Y.; Cai, W.; Xu, B. Profiles of phenolics, carotenoids and antioxidative capacities of thermal processed white, yellow, orange and purple sweet potatoes grown in Guilin, China. Food Sci. Hum. Wellness 2015, 4, 123–132. [Google Scholar] [CrossRef]
- AOAC. International Official Methods of Analysis of the Association Official Methods of Analysis of the Association of Official Analytical. In Chemists International, 20th ed.; AOAC International: Rockville, MD, USA, 2016; p. 3172. [Google Scholar]

| 2 Theta° | Intensity | hkl | Crystal Size (nm) |
|---|---|---|---|
| 28.615 | 2.40 | 110 | 40.99 |
| 29.372 | 2.20 | 110 | 35.70 |
| 32.321 | 100.00 | 110 | 34.46 |
| 34.507 | 3.10 | 111 | 39.61 |
| 35.544 | 8.50 | 111 | 26.06 |
| 39.544 | 0.80 | 200 | 28.13 |
| 67.517 | 2.40 | 310 | 88.80 |
| Fungi | Concentration (mg/mL) | ||
|---|---|---|---|
| 1.5 | 3 | 4.5 | |
| Botrytis cinerea (OR770482) | 66.66 | 66.66 | 75.0 |
| Rhodotorula mucilaginosa (OR770483) | 14.29 | 42.58 | 42.58 |
| Penicillium expansum (OR770484) | 58.33 | 58.33 | 58.33 |
| Alternaria alternata (OR770485) | 42.86 | 42.86 | 42.86 |
| Penicillium italicum (OR770486) | 0 | 62.75 | 68.75 |
| Stemphylium vesicarium (OR770487) | 0 | 20 | 20 |
| Fungi | Days | ||
|---|---|---|---|
| 2 | 4 | 7 | |
| Botrytis cinerea | 0 | 68 | 100 |
| Rhodotorula mucilaginosa | 16 | 64 | 100 |
| Penicillium expansum | 55 | 100 | - |
| Alternaria alternata | 20 | 96 | 100 |
| Penicillium italicum | 55 | 100 | - |
| Stemphylium vesicarium | 0 | 60 | 100 |
Disclaimer/Publisher’s Note: The statements, opinions and data contained in all publications are solely those of the individual author(s) and contributor(s) and not of MDPI and/or the editor(s). MDPI and/or the editor(s) disclaim responsibility for any injury to people or property resulting from any ideas, methods, instructions or products referred to in the content. |
© 2024 by the authors. Licensee MDPI, Basel, Switzerland. This article is an open access article distributed under the terms and conditions of the Creative Commons Attribution (CC BY) license (https://creativecommons.org/licenses/by/4.0/).
Share and Cite
Hamouda, R.A.; Almaghrabi, F.Q.; Alharbi, O.M.; Al-Harbi, A.D.M.; Alsulami, R.M.; Alhumairi, A.M. Antifungal Activities of Biogenic Silver Nanoparticles Mediated by Marine Algae: In Vitro and In Vivo Insights of Coating Tomato Fruit to Protect against Penicillium italicum Blue Mold. Mar. Drugs 2024, 22, 225. https://doi.org/10.3390/md22050225
Hamouda RA, Almaghrabi FQ, Alharbi OM, Al-Harbi ADM, Alsulami RM, Alhumairi AM. Antifungal Activities of Biogenic Silver Nanoparticles Mediated by Marine Algae: In Vitro and In Vivo Insights of Coating Tomato Fruit to Protect against Penicillium italicum Blue Mold. Marine Drugs. 2024; 22(5):225. https://doi.org/10.3390/md22050225
Chicago/Turabian StyleHamouda, Ragaa A., Fatimah Q. Almaghrabi, Ohoud M. Alharbi, Abla D. M. Al-Harbi, Rahaf M. Alsulami, and Abrar M. Alhumairi. 2024. "Antifungal Activities of Biogenic Silver Nanoparticles Mediated by Marine Algae: In Vitro and In Vivo Insights of Coating Tomato Fruit to Protect against Penicillium italicum Blue Mold" Marine Drugs 22, no. 5: 225. https://doi.org/10.3390/md22050225
APA StyleHamouda, R. A., Almaghrabi, F. Q., Alharbi, O. M., Al-Harbi, A. D. M., Alsulami, R. M., & Alhumairi, A. M. (2024). Antifungal Activities of Biogenic Silver Nanoparticles Mediated by Marine Algae: In Vitro and In Vivo Insights of Coating Tomato Fruit to Protect against Penicillium italicum Blue Mold. Marine Drugs, 22(5), 225. https://doi.org/10.3390/md22050225

